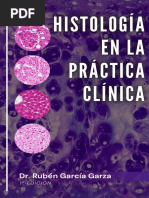

100%(10)100% encontró este documento útil (10 votos)
5K vistas277 páginasTexto Atlas Histologia Sepulveda PDF
Cargado por
Vania MartínezDerechos de autor
© © All Rights Reserved
Nos tomamos en serio los derechos de los contenidos. Si sospechas que se trata de tu contenido, reclámalo aquí.
Formatos disponibles
Descarga como PDF o lee en línea desde Scribd
100%(10)100% encontró este documento útil (10 votos)
5K vistas277 páginasTexto Atlas Histologia Sepulveda PDF
Cargado por
Vania MartínezDerechos de autor
© © All Rights Reserved
Nos tomamos en serio los derechos de los contenidos. Si sospechas que se trata de tu contenido, reclámalo aquí.
Formatos disponibles
Descarga como PDF o lee en línea desde Scribd
TEXTO ATLAS DE
HISTOLO GIA.
BIOLOGIA CELULAR Y TISYLAR ‘
Julio Septlveda Saavedra
ne
os
La célula es Ja unidad funcional y estructural bisica que
compone al cuerpo humano y al de todos los seres vivos. Por
Jotanto, para entender la estructura y funcién del organismo
completo, es fundamental conocer la estructura y la funcién.
de sus unidades componentes, es decir, las células. En los
organismos superiores existen varios niveles de organizacion,
biolégica: en primer término, las células, que son las unida
des, se organizan en tejidos; a continuacién éstos, ya sea de
uno o varios tipos de células, se unen para llevar a cabo una
funcién comiin, por ejemplo los tejidos epitelial, muscular,
conectivo o nervioso. Después, los tejidos se integran para
formar érganos que son estructuras mas complejas y que
efectiian funciones esenciales para la sobrevivencia del orga-
rnismo. Son ejemplos el corazén, los pulmones o los rifiones.
Por tltimo, estos drganos se agrupan para constituir apara-
tos 0 sistemas, que desempeiian funciones especificas con la
participacién de varios érganos.
En consecuencia, para comprender todos estos niveles
de organizacién biolbgica es esencial conocer primero la
vida de las cétulas (0 biologia celular) y le de los tefidos que
conforman (o biologia tisular).
‘Asimismo, en los procesos patoldgicos de un érgano 0
‘un sistema, causantes de algiin padecimiento en el ser huma
no, se observa que estas patologias se originan a nivel celular
Y que se manifiestan en el organismo completo. Por consi
{uiente, para los mecanismos que causan una enfermedad es
preciso conocer el estado de salud 0 normalidad de a célula
Este conocimiento implica a su vez el abordaje desde varios
puntos de vista: por un lado, la organizacién estructural 0
morfoldgica de la célula, que es el objeto de estudio de la
hhistologia; la composicién molecular y funcionamiento de
las moléculas que determinan la operacién normal y coordi
nada de las células, o biologia molecular de la célula; la bio-
‘quimica, que estudia las reacciones quimicas propias de la
materia viva y que se levan a cabo en todas las células para
mantener su integridad morfol6gica y funcional, y a fisiolo-
‘gia celular, que estudia los procesos realizados en las células,
normales, necesarios para mantener la integridad de las
células y su interaccién con otras células diferentes. La biolo-
gia celular y tisular analiza en forma integral estos aspectos
de la vida de las células. Uno de los primeros aspectos a estu-
diar es la estructura o morfologia normal de las células, tji-
dos y érganos componentes del organismo humano normal.
Para el estudio morfolégico de las células, tefidos y rganos
(histologia), que permite hacer una descripcién de a estruc-
tura de sus componentes, se recurre a una serie de métodos
para conseguir preparados histolégicos permanentes, lama-
dos laminillas o preparaciones, ya que los érganos son
gruesos ¥ es necesario obtener cortes finos, suficientemente
delgados para examinarse al microscopio 6ptico.
Los cortes se efectian con un aparato denominado
micrétomo, pero antes los tejidos deben pasar por diversos
tratamientos que constituyen la técnica histolégica y que
consiste en 10 etapas:
Obtencién de la muestra
Fijacion
Deshidratacién
‘Aclaramiento,
Preinclusién
Inclusién definitiva
Microtomia
Adhesién de los cortes
Tincién
Montaje
La técnica histolbgica se inicia con la obtencién de la
pieza o muestra bioldgica, que puede provenir de una biop-
sia de un paciente, un animal de experimentacién, o bien
mediante puncién, laparoscopia o endoscopia (0 incluso de
autopsia 0 necropsia)..
La biopsia consiste en escindir de un individuo una
porcién de tejido normal o patoldgico. Las biopsias pueden
conseguirse de varias formas: a) por raspado, que consiste
2 CAPITULO 1. IMPORTANCIA DE LA BIOLOGIA CELULAR Y TISULAR Y TECNICAS DE ESTUDIO DE CELULAS Y TENDOS
en tomar la muestra de superficies mucosas del cuerpo con el,
uso de un abatelenguas o cucharillas; b) por endoscopia, con,
obtencién de la muestra directamente de tejidos de las cavi-
dades corporales; c) por escisién directa, mediante un pro-
cedimiento quirirgico (previa anestesia), 0 d) por puncién,
que hace posible recoger muestras de tejido de Grganos inter-
nos y liquidos con agujas finas.
Sila muestra es de un érgano, debe realizarse un mues-
treo, que consiste en obtener pequefias porciones de tejido.
El tamafo ideal es de I em’, Inmediatamente debe sumergit-
se la muestra en una solucién fijadora (en un volumen 50
veces mayor al de la pieza). Esta solucién fijadora es un agen-
te que preserva la estructura 0 morfologia in vivo yla mayor
parte de los componentes tisulares.
Fijacion
‘A fin de evitar la destruccién de las células por sus propias
enzimas (autdlisis) 0 bacterias, los tejidos separados del
cuerpo de una persona u otro espécimen deben tratarse
inmediatamente después de su corte mediante un proceso
denominado fijacién. Este consiste en embeber la muestra
en un compuesto que debe tener las siguientes finalidades:
1. Preservar la morfologia y la estructura quimica de los,
componentes del tejido, de tal modo que la pieza a anali-
zar corresponda a su estado previo cuando los tejidos for-
‘maban parte del cuerpo del individuo vivo. Preservar
significa proteger del dafio y evitar el cambio minimo
estructural 0 molecular.
2. Endurecer los tejidos y hacerlos més resistentes para las
tapas siguientes de la técnica histolégica.
La fijacién puede realizarse por procesos fisicos, como
el calor (p. een bacteriologia) o el frio (congelamiento). En.
histologia se utiliza con frecuencia la fijacién quimica.
Para efectuar la fijacién quimica se emplea de manera
universal el formaldehido, por lo regular llamado formol,
(H-CHO). Este ¢s un gas disuelto en agua en una concentra-
cidn de 38% a partir del cual se prepara una dilucién al 10%
en agua destilada; asi queda listo para usarse en cualquier
muestra de tejidos.
En a investigacién biomédica, el formaldchido se pre-
para al diluir una solucién de cloruro de sodio al 0.9% 0 bien
en amortiguador de fosfatos a pH de 7.2 a 7.4.
Existen soluciones fijadoras simples y compuestas; las,
primeras se componen con un reactivo, como formalde!
alcohol etilico, acido acético, acido picrico, acido crémico,
‘entre otros més. Las segundas son mezclas de dos o mas
reactivos y tienen como finalidad mejorar o mantener las,
cualidades del fijador.
Deben mencionarse ciertos factores que pueden influir
‘en la fijacién, en primer término el tamaio de la muestra a
fijar; otros factores son el volumen del fjador, que debe ser
ssuficiente para permitir una adecuada penetracidn, asi como
la calidad, pureza y concentracién del compuesto activo del,
fijador.
Una vez que las muestras se han fijado deben encapsu-
larse en casetes apropiados y etiquetarse y luego lavarse en
‘agua corriente para retirar al final el exceso de fijador del
material,
Deshidratacién y aclaramiento
Las muestras que se retiran del fijador quedan inmersas en.
agua destilada, la cual impide que el agente de inclusidn, es,
decir, la parafina, las impregne. Para conseguir la infiltraciin
es necesario deshidratar y diafanizar los tejidos. Para ello se
somete el material a inmersiones progresivas en soluciones,
alcohdlicas graduales, de menor a mayor concentracién;,
son recomendables las siguientes: 60, 70, 80 0 96° y absoluto
de 100%. Esto tiene la finalidad de evitar una deshidrata-
ign stbita.
Una vez terminada la deshidratacién la técnica siguiente
es el aclaramiento, para lo cual se emplean agentes aclarado-
res, como solventes orgénicos y aromaticos (pe. xileno). El,
alcohol diluido, y otros reactivos utilizados para deshidratar,
no se mezclan con la parafina. Porlo tanto, los agentes acla-
adores son miscibles o solubles tanto en alcohol como en,
parafina.
El término aclarador se emplea como indicador de un
reactivo que proporciona un alto indice de refraccién alte
do, haciéndolo més o menos transparente (diafanizacién).
Entre los mejores solventes dela parafina figuran el ben-
ceno, tolueno, cloroformo y xileno; este iltimo es el més
utilizado.
Preinclusi6n en parafina
(impregnacién de parafina)
Esel método que le da solider.a los tejidos, al inciuirlos en un,
compuesto orginico en estado liquido que al solidificarse
sirve de soporte y ello permite obtener cortes delgados del
tejido. En la actualidad, la parafina es el compuesto més,
empleado en los laboratorios.
La parafina es una mezcla de hidrocarburos saturados
derivados del petroleo, con diferente punto de fusién; son s6
dos ala temperatura ambiente, blancos e insolubles en el agua,
pero solublesen xilol.Existen mezclas de parafina y polimeros,
sintéticos que mejoran la calidad de la impregnacién,
Inclusi6n definitiva y orientacién
adecuada de las muestras
La formacién de un bloque de parafina que contiene la mues-
tra de tejido se logra con la ayuda de una unidad de inclu-
sin, que consiste en un depésito que mantiene la parafina
liquida (a temperatura de 56 2 58°C) y una platina, cuya
superficie se mantiene a baja temperatura (0°C, +/- 1°).
Microtomia
Esel método mediante el cual se consiguen cortes delgados a
partir de los bloques de tejidos incluidos en parafina, Para,
ello se recurre al empleo de aparatos mecénicos, como el,
micrétomo rotatorio tipo Minot, o simplemente micréto-
mo, de parafina de cuchilla fija, 0 bien con adaptador para
navajas desechables.
Una ver obtenido el mimero deseado de cortes, éstos se
extienden y e os hace fltar en agua caliente (40 a 45°C) con
gelatina u otro agente adhesivo. Los pasos anteriores se ilus
tran en la figura 1-1,
Métodos de estudio
Luego de obtener las preparaciones histologicas (laminillas
con cortes), éstas siguen con el proceso de tincidn 0 colora-
+e.
Vesicula cubierta
Oa
@.
Vesfeula de membrana
Via reguads Espacio
extaceular
5. 13s vesiculas contindan avanzando a la cara
‘medial y posteriormente a la cara tons
6.Eila cara tans las protenas se clastican y
se envian en vesculas a diferentes destinos
‘como la via consttutva, va tegulads 0 a otros
‘organelos coma fos lsosomas
‘cubiertas y son especificas de esta via del aparato de Golgi
hacia los lisosomas, y de la via de endocitosis, es deci, de la
via que permite la introduccién de moléculas del espacio
extracelular hacia el interior de la célula a partir del plasma-
ema, Por este proceso también se incorporan fragmentos de
plasmalema para el recambio.
Lisosomas
Los lisosomas son organelos membranosos, formados por
vesiculas de tamafo variable, que se caracterizan por conte-
ner en su interior un grupo de enzimas hidrolasas acidas
(alrededor de 40 tipos de enzimas), que son capaces de
degradar casi a todas las moléculas orginicas que pasan a su
interior, o bien que entran en contacto con ellas, puesto que
también se liberan en ciertas condiciones. Este organelo se
forma a partir de la cara trans del aparato de Golgi, como ya
se mencioné, por medio de vesiculas cubiertas de clatrina,
que contienen a las enzimas lisosomales inactivas, que
glucoproteinas sintetizadas en el RER y que poseen una mar
caespecial para ser enviadas.a esta via, Tales vesiculas migran,
pierden la cubierta de clatrina y dejan expuestas otras seftales
de reconocimiento para que se fusionen con otras vesiculas
lisosomales mayores. Las vesiculas que contienen a las enzi
‘mas hidrolasas son inactivas, ya que requieren un medio
ambiente interno dcido, a un pH de 5.0, para que las enzimas
Invodvecion EL
ttconia
ie °®
‘S ° . °
apee 1. Los organelos senescentes
aque van ser degrdados son
‘odeados pr ura membrana
proveniente del RER
Bsc de RER
Q 7. an een
slapons = —
° cones rama que cntenen
las hidrolasas acidas y bomba
de protones.
Proceso digestivo
Hidrolasas dcidas
4. £1 contenido del autofagosoma
se mezca con las hidrolasas
4cidas e inci el proceso digestivo.
Figura 2-19. A. Esquema que ilusta y describe los pasos del proceso de autofagocitosis. 8. Micrografia que muestra cémo las membranas de reticu
lo-endoplasmico rugoso (1) empiezan a rodear a una porcién de citoplasma que contiene una mitocondtia (2). Microscopia electénica de transmisién.
‘C Mcragrafiaen la que se observa un autofagosoma con su membrana (1) y una porcién del citoplasma con organelos (2). Mitoscopiaelectrnica de
transmisién. 0. Micrografia que muestra un cuerpo autofagico con su membrana (1) y material en digestén (2). Microscopiaelectrénica de transi
sion. E Microgratia de un cuerpo autofégico con su membrana (1) y material en digestin (2). Mcroscopiaelecténica de transmisin.
30 CaPiuLo 2. La ceLuta
Bomba de
protones
Bacteria
Fagoctosis
latina
inactivas
1. La cul fagocita o pinocita y
forma vesiculas lamadas
fagosomas 0 pinosomas que
pueden o no estar cubiertas de
3.La vesicula ahora se llama
tendosoma taro
4. Las vesiculas cubietas de
clatrina provenientes de la
ara trans del aparato de Gola}
transport hidroasas dcidas
5. Estas vesiculs pierden su
cubieta y se fusionan con los
€endosomas tars pare formar
los heteralisosomas
2. nel ctoplasma la vesicula ¥-
endoctia pierde su cubierta que
es recilada y forma un *
endosoma temprano, que por
efecto de las bombas de
empieza a acidfcar su contenido
Figura 2-20. A. Esquema que ilustra y describe los pasos del proceso de digestion de material endacitado por fagocitosi y pinacitoss.B. Microgra-
fias que muestian la secuencia de la formacién de una vesicula pinoctica cubierta de catrna; obsérvense el material a pinocitar (1) y la cubierta de
clattina (2). Mictoscopia eleciénica de transmisién.€. Micrografias que muestran la secuencia de endocitosis de un trazador marcado con oro coloi-
dal; veanse la membrana plasmatica (1) y la formacin dela vesicula endacitica con postividad en su interior (2); destacan en la itima microgratia
|a proximidad de estas vesiculas (1) con un isosoma (2). Microscopia electronica de transmision.
se activen, Por lo tanto, cuando reciben del plasmalema
pequeiias ves{culas con material endocitado, que degradarin
los lisosomas, obtienen dela membrana de estas vesiculas un
sistema de bombas de protones, que esta integrado en la
‘membrana de la vesicula endocitica y que tiene la funcién de
disminuir el pH interno de los lisosomas, al bombear proto-
nes hacia el interior del organelo; de esta forma se activan las
enzimas para que sean funcionales y puedan llevar a cabo la
degradacién de otras moléculas.
Se considera que los lisosomas pueden tener los siguien-
tes origenes: a partir de areas del citoplasma en donde se
agrupan organelos envejecidos, que se degradan para su
recambio; estas éreas se encierran en una membrana que pro-
viene del RE y se forma una vesicula que se conoce como
autofagosoma. Dicha vesicula se funde con los lisosomas,
que descargan su contenido enzimitico e incorporan las
bombas de protones, hasta iniciar ast el proceso de degrada-
cidn (fig. 2-19-E). Otra fuente de origen de los lisosomas es
a partir de la formacién de vesiculas provenientes del plasma-
ema. Estas pueden originarse en material particulado, por
ejemplo microorganismos o fragmentos de células, en el pro-
eso llamado fagocitosis, o bien que endocitan hasta molécu-
las en suspension en el proceso llamado pinocitosis. En
ambos procesos, las vesiculas pasan inicialmente a una estruc~
tura sacular llamada endosoma temprano y ahi se inicia la
acidificacin del contenido, mediante la actividad de las bom-
bas de protones membranales, y se transforma en el denomi-
nado endosoma tardio, que posteriormente recibe la
descarga de vesiculas lisosomales, que liberan a las enzimas
hhidroliticas necesarias para la degradacién del contenido. Asi
se forman los llamados heterolisosomas, los cuales contie~
‘nen material extracelular, degradado por el sistema lisosomal
(fig. 2-20A-C). Esto puede representar un mecanismo de
defensa 0 bien la incorporacién de moléculas que forman
precursores de la sintesis de moléculas tiles ala célula.
Con el microscopio éptico de campo claro es posible
identificar alos lisosomas por medio de reacciones histoq
‘micas, que demuestran la actividad de algunas de las hidro-
Jasas icidas, por ejemplo la fosfatasa dcida que se considera
tuna enzima marcadora de este organelo (fig. 2-21 y B). Con.
el microscopio electrénico de transmisién se reconocen
‘cuerpos electrodensos de tamatio y electrodensidad varia-
bles. También se pueden identificar por medio de reacciones
hhistoquimicas para la deteccién de la actividad enzimética
‘specifica lisosomal. Se pueden observar enzimas especificas
‘con técnicas de inmunomarcaje con oro coloidal (fig. 2-22),
Se distinguen de otros cuerpos electrodensos porque su con-
tenido presenta una electrodensidad variable, cuando ya ha
‘ocurrido la degradacién de moléculas (fig. 2-22B). En los
lisosomas que han degradado intensamente a las membranas
de otros organelos se empiezan a acumular residuos de lipi-
dos peroxidados no degradables, que al aumentar de tamano
pueden hacerse visibles al microscopio dptico en la forma de
cuerpos que contienen un pigmento, conocido como lipo-
fuesina (fig. 2-22C), también identificable con el microsco-
pio electrénico de transmisién. A este pigmento inerte se lo
considera una inclusién celular. Algunas células que hal
tualmente no se dividen y que acumulan estos productos
finales resultantes del recambio y la degradacién de sus org
nelos son las células del muisculo estriado cardiaco o las neu-
ronas. Se lo conoce también como pigmento de la edad 0
del envejecimiento,
Enfermedades lisosomales
Las enfermedades lisosomales se deben a la existencia de
‘mutaciones que afectan a alguna de las 40 enzimas presen-
tes en el organelo. Segiin sea la enzima afectada, se origina
el almacenamiento de precursores especificos de la activi-
dad de esa enzima y la falta del producto normal. Una
excepcién es el caso de la enfermedad I, en la que no hay
hidrolasas porque no se transportan de modo adecuado
desde el aparato de Golgi, por falta de la sefial necesaria, En
Jas enfermedades lisosomales con aciimulo de sustratos no
degradados, éstos pueden alcanzar niveles téxicos. Son
‘ejemplos las mucopolisacaridosis como los sindromes de
Hurler o Hunter. Ambos causan sordera y lesiones en el sis-
tema nervioso central. La acumulacién de ceramida acida
provoca la enfermedad de Farber, que es letal durante el
primer aio de vida. La enfermedad de Tay-Sachs da lugar a
Ja acumulacién de ganglidsidos en el cerebro. El llamado
sindrome de Gaucher es la enfermedad lisosomal més
invedvecén NI
Hidrolasas cidas
Fosfatasa dcida
Ribonucieasa|
Desoxinibonucleasa
Proteasa
suifatasa
tipasa
Bralucuronidasa
Material
de digestion
Usosémma
1 Figura 221. a. squeme que muesta un lsosoma y algunas de sus
enzimas digestvas mas frecuentes. 8. Fotomicograta de varias clu
las con pstivdaden su ctoplasma parla eacio histoquimic para
identificar fosfatasa dcida (1); se observan ademas los nucleos (2) y
un segment detejdo 6500 (3).
‘comin y se debe a la falta de una enzima glucosilceramini-
dasa y ocasiona una lipidosis.
Peroxisomas
Los peroxisomas son organelos membranosos semejantes en
su aspecto a los lisosomas. Estin presentes en un niimero
variable, alrededor de 500 por célula. También estén limita-
dos por una membrana sencilla, pero no provienen del apa-
rato de Golgi sino mas directamente del RE (fig. 2-23A),
Contienen enzimas liticas oxidativas (cerca de 50), que no
se glucosilan en el aparato de Golgi, sino que se sintetizan
por completo en el citoplasma y presentan un péptido de
sefializacin que las envia de manera directa al peroxisoma,
CaptruLo 2. La ceLULA
= 4
A. Microgafia que muestra isosomas con positvidad para
la reaccién citaquimica para identificarfosfatasa dcida (1); se observa
‘ademas un segmento del nicleo (2). Micrscopia electronica de trans-
‘mision, B. Micografia de isosomas con cuerpas residuals electroden
505 en su interior (flechas).€.Fotomicrografia del citoplasma (1) de una
‘neurona con abundantes grénulos de lipofucsna (2) Hy E.
en donde atraviesan la membrana para alojarse en el interior
© fijarse a la membrana peroxisomal (fig. 2-23B y D). En el
peroxisoma se degradan el écido tirico, aminodcidos y écidos
grasos de cadena larga y muy larga, asi como las purinas
AMP y GMP. También participan en reacciones de sintesis
del colesterol, los écidos biliares y la mielina. El peréxido de
hidrdgeno resultante de sus reacciones metabélicas se degra-
da ahi mismo por accién de la enzima catalasa, que es la
enzima marcadora del organelo. Cuando se observan cuer-
pos densos en la célula, s6lo se distinguen de los lisosomas
por medio de la demostracién de la actividad de enzimas
‘marcadoras, como la fosfatasa dcida para los isosomas, como
ya se menciond, y la catalasa para los peroxisomas (fig,
2-23C). Los peroxisomas se dividen por fisién y proliferan en.
forma natural o inducida por efecto de farmacos 0 contami-
nantes ambientales.
Enfermedades peroxisomales
Algunas enfermedades hereditarias poco frecuentes se deben
a mutaciones de las enzimas peroxisomales, como el caso de
Ja adrenoleucodistrofia ligada al cromosoma X, que se cara
teriza por el deterioro de las vainas de mielina (desmieliniza-
ccién) que causa grados variables de paresia y paralisis grave
Enel sindrome de Zellweger existe un transporte defectuoso
de las enzimas peroxisomales en el higado, rifién y cerebro.
Fs un trastorno letal en el cual los individuos afectados no
sobreviven més allé de los seis meses.
Los proteasomas son complejos de enzimas proteasas cito-
plasmiticas, encargadas de degradar proteinas mal forma-
das, defectuosas o envejecidas que entran a un ciclo de
recambio. Sin embargo, también se degradan proteins regu-
ladoras de interés, que previamente se matcan con moléculas
de un polipéptido llamado ubiquitina. Una vez que se forma
tun complejo proteina-ubiquitina, entra en contacto con el
proteasoma, en el cual las proteinas se degradan por laaccién
de proteasas (figs.2-24 y 2-25), Otras proteinas que se degra-
dan por esta via son las que controlan la proliferacion y
supervivencia celular. Las células cancerosas dependen para
su proliferacién de la destruccién de estas proteinas regula-
doras; por lo tanto, el proteasoma se ha convertido en el
blanco de los farmacos anticancerosos. Se han probado ya
medicamentos que actian sobre el proteasoma para el trata-
miento de un cancer humano: el mieloma miltiple.
El citoesqueleto es un conjunto de estructuras filamentosas
que forman una compleja red dentro de la célula, tanto en el
citoplasma como en el nticleo. Esta red tiene funciones
estructurales y de soporte y dindmicas, ya que algunos
tipos de filamentos intervienen en todos los movimientos
intracelulares o de la célula completa (fig. 2-26A). Estos fila-
‘mentos estén formados por proteinas especificas, que se
enlazan entre si para formar estructuras mayores. Se distin-
guen los siguientes componentes del citoesqueleto: los
microtibulos, los filamentos delgados o de actina y los
filamentos intermedios. Los filamentos delgados y los micro-
tuibulos son estructuras muy dinémicas que constantemente
se ensamblan a partir de monémeros y desensamblan; de
esta caracteristica dependen muchas de las funciones en que
Introduccion
seis oes ee peeve
petoxisomales en el
citoplasma Fison
o Peroxssoma
6=
J Figura 2-23. a. Esquera que representa los sitios de sintess de las proteinas de membranas y enzimas peroxisomales y la prlifleracion de este
‘oxganelo. B,Fotomicrogafia de élulas en cultivo que muestranposiividad para la proteina de membrana peroxisomal70 (PMP-70) en el ctoplasma
(1); también se marcaron os filamentos de actina (2) y os nicleos (3). Inmunohistoquimica. €. Micrografia que muestra peroxisomas pasitvos para
Ta reaccin citaquimica para la cataasa (1); se identiican ademas algunas mitocondras (2). Micrscopia electronica de transmision.D. Micografia
en la que se observan peroxisomas con positvidad para la identificacion de catalasa con inmunomarcaje con oro colidal (1); se reconocen ademés
‘algunas mitocondrias (2) y una porcidn del nicleo (3). Inmunacitoquimica y microscopia electronica de transmisio.
de T iting
| mrad pesos
| b
aa e@
gj =a
Fragmentos Go,
de péptidos
I Figura 224. Reresentacion del proceso de destucién de proteins por el proteasome
34 Captruo 2. Lactua
1 Figura 2-25. A. Esquema que muestra la forma de un proteosoma.
8. Microgafia que muestra a aparencia de un proteosoma abservado
on microscopa electronica de ansmisin.
intervienen. En cambio, los filamentos intermedios son esta-
bles, es decir, desde su formacién permanecen ensamblados
y estén integrados por varios tipos de proteinas que son
especificas de cada tejido (fig. 2-26B). En particular, tienen a
su cargo funciones de soporte. Todos los componentes del
citoesqueleto se pueden observar con el microscopio electr6-
nico de transmisién. Con el microscopio dptico de campo
claro se puede demostrar su presencia mediante la técnica de
inmunohistoquimica, con anticuerpos especificos antitubu-
lina, antiactina o antiprotefnas componentes de los flamen-
tos intermedios,
Microtdbulos
Los microtibulos participan en varias funciones vitales para
la célula, entre ellas Ja integracién del huso acromético
durante as divisiones celulares, lo que da lugar ala migracién
de los cromosomas a las células hijas. Estin presentes en los
a
apa de cllos
Centropiasma
Flamentos
e acina
uniones
inecenes
mcrotdbbs
lamentos ccnbulos filaments
NS de acne inermedis
Unines de andlajeé Neo __‘filamentas
dela ceva imermedios
8 Rbosomas
zetia
embana endoplsmico
plastica
microfilaments
de actna
Filamentos
intermedios
1 ¥ {
2D? 0 &2 0
Mondmero
de acting
‘subunidad
fibvosa
Dinero /Monémero~ Manémero
de ubulina de tubulna Bde tubulin
T Figura 2-26. A. Esquema de los componentes del citoesqueleto y su distribucion en la célula. B. Esquema que ilustra la interaccién del citoesquele-
to con los organelos celulares; se muestran ademas sus components.
cilios y flagelos de algunas células y les confieren la movili-
dad. También se encargan de los movimientos de los orga-
nelos y vesiculas intracelulares por medio de su relacién con
proteinas motoras. Muchas de sus funciones se llevan a cabo
debido a su capacidad para ensamblarse, con el consumo de
energia, y para desensamblarse, segiin sean las necesidades
celulares. La funcionalidad de los microtibulos esta mediada
por una estructura llamada centrosoma, ocupada por un par
de estructuras formadas por microtibulos, los denominados
‘centriolos. Se encuentran cerca del nticleo celular. Todos los
microtibulos citoplasmicos parten de esta estructura (cen-
triolos), en la cual ocurre su nucleacién y se hallan en un
‘constante proceso de alargamiento y pérdida de longitud
Los microtibulos estén formados por la conexién de
subunidades proteicas, en forma de heterodimeros, forma-
dos por dos moléculas de tubulina: a y B (fig. 2-27B). Estos
heterodimeros se vinculan y forman unas estructuras linea~
les que se pueden observar por medio del microscopio elec
‘trdnico de transmisién y que se conocen con el nombre de
protofilamentos (fig. 2-27C y D). Por consiguiente, la pared
del microtubulo esta integrada por 13 protofilamentos, cuya
longitud varia de acuerdo con las necesidades de la célula. En
el proceso de crecimiento o elongacién de los microtiibulos
Extremo +
GIP GIP GDP GIP GpP GTP
Mondmeros fxtvero
de tubulina
Introduccién
se ensamblan nuevas subunidades del heterodimero a-P y se
activan por la presencia de una molécula de GTP (trifosfato
de guanosina), que favorece su unién al extremo del micro-
tubulo mas alejado del centrosoma. Una vez que se ha
ensamblado el heterodimero se hidroliza el GTP hasta GDP
(difosfato de guanosina) (fig. 2-274). Se ha descrito la exis-
tencia en el microtibulo de un extremo positivo, que es el
sitio rico en GTP y que no deja de incorporar nuevos hetero-
dimeros hasta que entra en contacto con la membrana de
algin organelo 0 cromosoma. Si esto no sucede, el extremo
positivo se modifica, al estar ocupado ahora por dimeros
relacionados con GDP. Esto impide el crecimiento y ademas
provoca una pérdida de suBunidades, lo que determina una
disminucién de la longitud del microtibulo. Cuando el
microtabulo en crecimiento se vincula con alguna mem-
brana de organelo, se le unen varias proteinas, las cuales le
confieren estabilidad y evitan que se desensamble. Los
microtiibulos estabilizados participan en la organizacién del
citoplasma y facilitan el movimiento de vesiculas y organelos
membranosos, de tal modo que participan en el movimiento
de la célula y el transporte microtubular.
Algunos firmacos, como la colquicina, se unen a las
subunidades de tubulina y bloquean el ensamblaje de los
1 Figura 2-27. A. Esquema que representa el proceso de polimerizacién de los microtibulos. 8. Fotomicrografia de células en cultivo que muestian
positvided para la tubulina (1); también se marcaron los ncleos (2). Inmunohistoquimics. €. Mictogratia que muestra microtUbulos cortados en
sentido longitudinal; obsérvense los bordes (1) y la luz (2). Microscopia elecrdnica de transmision.D. Micrograffa que muestra microtabulos cortados
fen sentido transversal; véanse los protoilamentos (1) y la luz (2). Microscopia eleciénica de transmisién,
36 CamTULo2. Laces
1 Figura 2:28. a tsquema que ist las proteinas motrscnesnay dneina, los components clulares que transpotan ys lac con ls micro
bulos.B. squemesy mecrogratie qe usta las protenes motores cnesinaydinene, Microscopio elecronca de ons
‘microtibulos. Esto afecta sobre todo a la polimerizacién de co que también se ha empleado contra el cincer es el taxol,
Jas subunidades de tubulina que forman el huso acromitico_que se une ala tubulina que ya esta ensamblada en el micro-
durante la mitosis, o cual impide la formacién de estaestruc- _~ tibulo e impide su despolimerizacién, lo que también detie
tura y detienen la mitosis en la metafase. Este farmaco se ha _ne la mitosis en la metafase.
utilizado para detener la divisin celular en células que pro- Se han identificado algunas proteinas, llamadas moto-
liferan répidamente, como las células malignas. Otro farma- ras porque participan en el movimiento de organelos mem:
a Monimens deci :
o o 9
g—o Sp Xp
°
1 Figura 229. a squema que sta el proceso de polimeszacion de los mirolamentos de actna. 8. Fotomicrograta de cls en cuitivo que
tvestionpostvidd para ctna (1), tambien se marcacon el compleo del poronuceat (2) ls ncleos (3). Inmunchistoquimica.€. Micrograta
{ue muestra haces de mkrolmetos de acti (1); compsrense con el dsmetro de los flamenosintermedios (2). ncrescopia elecrénia de
tTansmisin,B, Micograta que muesta mirotlamentos de actinaorgenizadosen forma de red (1) por debajo de lo membrana plasmatca (2)
dicoscopia elecenica de brn.
ee ee)
ovine Rheeagereeeeeee eel
LLL
branosos a lo largo de la red microtubular. Estas son la
dineina, que tiene un extremo globular con actividad de
ATPasa y otro en forma de una cola que se relaciona con
moléculas de la membrana de organelos o vesiculas que se
transportan de un sitio a otro, Esta proteina permite el des
plazamiento de organelos o vesiculas hacia el centrosoma, ¢s
decir, hacia el extremo del microtibulo; por su parte, otra
proteina motora, la cinesina, tiene la misma funcién, sélo
que desplaza estructuras membranosas hacia el extremo ale
jado del centrosoma o extremo positivo (fig. 2-28A y B),
Estas interacciones son dependientes de la hidrélisis del ATP
y la consecuente liberacién de energia para que ocurran.
Microfilamentos
Los microfilamentos estan formados por subunidades de la
proteina actina, cuya presencia se ha demostrado en todas las
células, incluido el niicleo celular; abundan més en las células
musculares, en las cuales se identifican cuatro de las seis iso
formas que se han descrito para esta proteina, Las otras dos
isoformas se encuentran en otras células. Junto con los micro
Introduccién
Figura 2-30. A. Esquema del proceso de polimerizaciin de ls fila
‘mentos intermedi. B, Fotomicrografia de células en cocultivo con
‘neuronas positvas para neuroilamentos (1) junto con astrcits pos
tivas para proteina dcida ibrar lial (FAP) (2). Inmunohistoquimica.
€ fFolomiciografia de una céula en cultivo que muestra positvidad
ara vimentina (1); se marcafon ademas el aparata de Golgi (2) y el
ricleo (3). Innwnohistoquimica. D, Micrografia que muestra filamen
tas intermedios en el citoplasma de una célua (lechas). Microscopia
electrénica de transmisén,
tiibulos, proveen a las células de un marco de soporte. Se pro-
yectan desde la periferia hacia el micleo de la célula (fig. 2-29B
y ©), En algunas células se concentran inmediatamente por
debajo del plasmalema y forman lo que se conoce como cor.
teza celular (fig. 2-29D). Estos microfilamentos tienen un
didmetro de 8 nm, En las células musculares se encargan de la
contraceién muscular, en relacién con otra proteina llamada
miosina, En otros tipos celulares regulan el estado fisico del
citoplasma, es decir, las transformaciones gel-sol, el movi
miento y la formacién de los anillos contractiles que aparecen
al final de la mitosis, para la separacién de las cétulas hijas,
Estas funciones se levan a cabo por el proceso de cambio
molecular que experimenta la actina, que deja de ser una pro-
teina globular libre, llamada actina-G, para vincularse con
otras moléculas de actina, como actina-F, y dar lugar ala for
macién de los microfilamentos (fig. 2-29). En el niicleo se
relaciona con la cromatina; en la actualidad se cree que inter
viene en la regulacién de la transcripcién. Para llevar a cabo
sus funciones, los microfilamentos se relacionan con las pro
teinas vinculadas con la actina, que regulan su estructura y la
38 Cartruo 2. LactULA
polimerizacién de las subunidades de actina-G. Tales son los
casos de la profilina y la timosina, que al unirse a la actina-G
evitan su polimerizacién. Otras proteinas enlazan entre s{ a
varios microfilamentos para formar haces, como la fimbrina
y la villina, o bien inducen su fragmentacién o despolimeri-
zacién, como la gelsolina.
Los microfilamentos poseen diferencias en sus extre-
‘mos, ya que en uno de ellos se incorporan con mayor rapidez
nuevas subunidades de actina-G, lo que provoca su elonga-
cidn. A este extremo también se lo conoce como positive (+),
mientras que el otro extremo, o negativo (-~),tiendea agregar
subunidades de actina-G més lentamente. Cuando se estabi-
liza la elongacién de los microfilamentos, en el extremo posi-
tivo, se adjuntan otras proteinas, Ilamadas de casquete, que
ccubren el extremo del microfilamento y evitan que se agre-
‘guen subunidades adicionales de actina.
‘Mientras que en la mayor parte de las células la actina se
‘encuentra en forma dinamica, y cambia su disposicién mole-
cular entre actina-G y actina-F, en las células musculares se
halla en la forma de microfilamentos estables, que no se poli-
‘merizan y despolimerizan sucesivamente. En la célula mus-
cular estriada, los microfilamentos de actina estan vinculados
on otra protefna llamada miosina, de la cual también se han
identificado varias isoformas. De la interaccién de estas dos
proteinas, la actina y la miosina, resulta la contraccién mus-
cular. En el misculo estriado, la miosina crea filamentos
sgruesos de un diémetro de 16 nm, En el capitulo correspon-
diente al tejido muscular se describe el mecanismo de la con-
traceién muscular
Filamentos intermedios
AA diferencia de los microtibulos y los microfilamentos, los
filamentos intermedios estin constituidos por subunidades
proteicas que forman estructuras muy estables, que no sufren
ciclos de polimerizacién y despolimerizacién. Tienen un
grosor de 10 nm, Proporcionan a las células soporte estruc-
tural y proteccién (fig. 2-30A y D). Las subunidades que los
componen son proteinas especificas del tejido en donde se
localizan. Por este motivo, la deteccién de su presencia por
‘métodos inmunohistoquimicos, mediante anticuerpos espe-
cificos dirigidos contra las proteinas que los componen, es
indicativa del origen de células y tejidos. En consecuencia,
Jos filamentos de citoqueratina son especificos para las célu-
las de los tejidos epiteliales y sus derivados. Los filamentos de
vimentina estin presentes en las células de origen mesen-
quimatoso, como son las del tejido conectivo y todas sus
variedades (fig. 2-30C). Los filamentos de desmina son pro-
pios del tejido muscular liso, aunque también se identifican
entre las proteinas de las bandas Z del muisculo estriado. Los
neurofilamentos estin presentes en las células del tejido
nervioso (ig, 2-30B). Los filamentos iminas se hallan en el
niicleo de todas las células, mantienen su estructura y parti-
cipan en la fragmentacién y reorganizacién de la envoltura
nuclear durante la mitosis. Los filamentos de nestina se loca~
lizan en las neuronas y se relacionan con su crecimiento.
Inclusiones
Las inclusiones, que se pueden encontrar en algunas células,
pueden ser por su origen exdgenas 0 endégenas. Las exdge-
nasson aquellas que la célula ha adquirido del medio ambien-
te externo, por ejemplo el material endocitado, como las
particulas de polvo que se observan en el interior de los
™macréfagos alveolares en el pulmén, Pueden corresponder a
particulas de carbén u otros elementos. Las inclusiones
‘endégenas son las que tienen origen en la misma célula, por
ejemplo pigmentos, como la melanina que se observa sobre
todo en la epidermis y la lipofucsina que aparece en las célu-
las del miisculo estriado cardiaco y las neuronas, resultado
de la actividad lisosomal y que aparece con la edad (fig.
2-314 y B). Se acumulan en ciertos tipos de células. Otras
inclusiones endégenas son dep6sitos de nutrientes, como las
particulas de glucégeno, que se reconocen en el masculo
estriado esquelético o el higado (fig. 2-32A y B). Las gotas de
lipidos, muy abundantes en el tejido adiposo 0 el higado, son
las mas frecuentes (fig. 2-32C y D). Otras inclusiones son los
ristales formados por el depdsito de proteinas, como aque-
T Figura 2-31. A. Fotomicrogratia de epidermis en la que se observa una capa de células con granulos de melanina en el citoplasma (1); se identifican
también sus ndcleos (2).H yE. B. Micrografia del citoplasma de una célula que contiene grénulos de melanina (1); se observa ademas una porcién
del nicleo (2). Microscopi eleciénica de transmisin.
Nocleo
{A Fotomicrografia de células del higado con abundantes depésitos de glucégeno en su citoplasma (1); se recanocen también sus
icles (2). PAS. B. Micrografia que muestra grdnulos de glucbgeno en el citoplasma de una célla (1); también se reconacen cisternas de reticulo
endopldsmico rugoso (2) con ribosomas (3). Microscopia electrénica de transmisén. €. Fotomicrografia de célula del higado con gotas delipidos en
54 citoplasma (1); se observan también los nicleos (2). Histoquimica con rojo oleaso.D. Micrografia que muestra gotas de lipidos en el citoplasma de
tuna célula (fechas) Microscopia electrénica de transmisién, €, Fotomicrografia de células de Leydig con crstales en su citoplasma (1); se observan
también sus nicleos (2) Tricrémico de Masson. F. Micrografia que muestra crstales en el citoplasma de una célula de Leydig (1), ademas de pig
mentos (2) y mitocondiias (3). Microscopia electronica de transmision
Hlos que estan presentes en las células de Leydig del testiculo
(fig. 2-32E y F). Todas estas estructuras son transitorias y
sélo se encuentran en determinados tipos de células y cuan-
do se aislan son metabélicamente inertes,
El nticleo es el organelo celular mas notable observado en las
preparaciones histolégicas comunes y es también el organelo
de mayor tamano (fig. 2-33). Esto se correlaciona con la
importancia que representa el niicleo para la célula y el orga-
nismo. En el micleo se encuentra almacenada la informacién
(genes) que, al expresarse ya sea en ARN y/o proteinas,
determina las caracteristicas estructurales y funcionales que
se observan en las células, los tejidos, los Srganos y el indivi
duo en su totalidad.
La posibilidad de reconocer diferentes estructuras y
funciones en el organismo supone que existe una expresion
diferencial de dicha informacién, Si cada una de las células
expresara todos los genes presentes en el niicleo, entonces
40 Caputo 2. LAcELULA
} Figura 2-33. Fotomicrogratia de ganglio nervioso que muestra varios
9
tipos de célulasy la forma de sus nécleos, neurona (1), célula satelite
(2), célula de Schwann (3), céula endotelial (4) H y E+ azul de met:
leno.
todas las células tendrian una estructura y funcién similares
; Por consiguiente, no habria distincién entre los tejidos y
Fibra rtiulares
(colagens tipo i)
A
rca de acon SEA ris ce nen
(colagena tp
(colagena tipo Wy
‘A. Fotomicrografia de inén que muestra la positvidad alos glucosaminoglucanos de la membrana basal (Hlechas) Acido peryédico de
Schiff (PAS). 8. Esquema de los componentes de la membrana basal. €. Microgafia de la membrana basal de una célula eptelial (1), lSmina licida
(2), lamina densa (3), Lamina reticular (4), placas de fjacién (5). Microscopia electronica de transmisin. B, Microgratia de la membrana basal de
célUlas epiteliales (1), [mina densa de la lamina basal (2), tejido conectvo (3). Microscopia elect nica de bartido,
Factina
Figura 3-13. A. Esquema que muestra la localizacién de laintegrina,
las subunidades que la integran y los sitios de unién intracelular
B.Fotomicrograia de lapel que revetala positividad para la integrina
43 1 (flechas). Inmunofiuorescencia
Lamina basal
Las imagenes de la lamina basal mediante microscopia elec
trdnica de transmisin ponen de manifesto sus dos regiones
(fig. 3-128):
1. Lamina hicida, Es una regidn electrolacida de alrededor
de 50 nm de espesor que se localiza justamente por deba
jo del epitelio. Consiste sobre todo de glucoproteinas
membrana basal QI
1 Figura 3-14. a equema de una adhesin focly las proeinas y
fiamentos quel forman,@. Micografia de un oblast (1) en col
tivo en la que se observa las polongaciones citoplasmstiesy fas
achesianesfcaes para su migracion (fechas), Mosconi elecén
ca de baida
extracelulares, como laminina y entactina, ademés del
glucosaminoglucano perlecano y una porcién de las pro
teinas transmembranales integrinas, que en su regién
intracelular se unen al citoesqueleto para fjar las células,
epiteliales.
2. Lamina densa. Es la region electrodensa de alrededor de
50 nm de espesor que se localiza en un plano més profun-
do respecto de la limina licida. Esta capa consiste en par-
ticular en una malla de coldgena tipo IV, ademés de
colagena tipo VII. La lamina densa esté cubierta en ambos
lados por perlecano.
La lamina basal funciona como filtro molecular y como
tun apoyo firme para el epitelio suprayacente, La funcién de
filtracién se debe a la malla entretejida que forma la coligena
de tipo TV con poros de tamafo especifico; las cargas negati-
vvas del sulfato de heparin también restringen el paso de
moléculas de carga negativa.
62 CAPITULO 3. MATRIZ EXTRACELULAR
Plectina
{ vemidesmosorna
Queatinas
Lamininas
Flamentos de queratina
Hemidesmosoma
Lamina lbida
Lamina densa
Falls de fjacén
PRE ere
oaks
1 Figura 3-15. a. tsquema que muestra un hemidesmosomay los le
mmentos que fo inteyan, 8. Micografia den hemidesmosoma, si
un con las protenas y fib de la membrana basal y el teido
-conectivo subyacente. Microscopia electronica de transmision.
Algunas funciones adicionales de la kimina basal son:
dirigir la migracién de las células a lo largo de su superficie
durante la etapa embrionaria y la reepitelizacién durante la
reparacién de las heridas, En los misculos, la limina externa
favorece el restablecimiento de las uniones neuromusculares,
durante la regeneracién de los nervios motores.
Lamina reticular
Los fibroblastos elaboran esta capa de espesor variable segiin
sea el grado de las fuerzas de friccién que recibe el epitelio
suprayacente; est compuesta por coldgenas de los tipos I y
IIL. Esta capa se encuentra entre la lamina basal y el tefido
conectivo subyacente. Es muy gruesa en la piel y muy delga-
T Figura 3-16. a. Esquema que muestra las proteinas intracelulares y
extracelulares de una fibra muscular y a lina externa, respectiva-
mente. B. Fotomicrografia de musculo esquelético que muestra la
positivdad para c-distroglucano. inmunohistoquimica.€. Fotomicto-
‘gratia de misculo esquelético que muestra la positvidad para
‘a-sarcoglucano (lechas). Inmunchistoquimica
da por debajo del epitelio de los tabiques interalveolares del
pulmén,
Las fibras de colégena de los tipos 1 y Ill interaccionan
con las placas de fijacién de la colagena tipo IV y con las.
fibrillas de fijacién de la colgena tipo VII y se fijan a ellas,
(fig. 3-12C). Asimismo, los grupos bisicos de las fibras de
coligenas forman enlaces con los grupos dcidos de los GAG.
‘que rodean ala kimina densa y con la fibronectina de la kimi:
na licida, lo cual hace més estable la fijacién de la lamina
basal a la Limina reticular y al tejido conectivo subyacente
(fig. 3-120).
Integrinas y distroglucanos
Las integrinas son una familia de més de 24 proteinas trans-
membranales distintas entre si, pero que realizan funciones
semejantes a los receptores de la membrana celular, ya que
forman enlaces con ligando. Sin embargo, a diferencia de
Jos receptores, son mucho mas numerosas y sus regiones
citoplasmaticas se encuentran fijadas al citoesqueleto; sus
ligandos no son moléculas de sefialamiento, sino miembros
estructurales de la matriz extracelular, como cokigena, lami-
nina y fibronectina.
En términos estructurales, las integrinas son heterodi
meros (~25 000 Da) compuestos por cadenas glucoproteini:
cas ay B (se han descrito alrededor de 18 subunidades a y
‘ocho subunidades B) (fig. 3-13A), cuyos extremos carboxilo
estin enlazados con la talina y actinina a del citoesqueleto y,
debido a que lo unen con macromoléculas de la matriz extra-
celular, a las integrinas también se las conoce como enlaza-
dores transmembranales (fig. 3-13).
La cadena a de la molécula de integrina fija Ca** 0
Mg’, cationes divalentes necesarios para la conservacién de
Ia fijacién apropiada con el ligand.
vias y awinpscts
Las integrinas funcionan de manera importante en la
conservacién de las adhesiones focales (fig. 3-144); estas
estructuras son necesarias para la fijacién de células como
los fibroblastos con la matriz extracelular (fig. 3-14B); las
adhesiones focales también favorecen la migracién celular.
En las adhesiones focales, los filamentos de actina del citoes-
queleto se fijan a la subunidad 6 de las integrinas con la ayu-
da de proteinas como a-actinina, vinculina y talina,
tra funcién de las integrins es su participacién en la
formacién de hemidesmosomas (fig. 3-15A y B), lo cual
ocurre cuando la integrina a6 64 interacciona con los fila-
‘mentos intermedios intracelulares a través de proteinas
como la plectina y BP230. En el dominio extracelular, la inte-
grina se une con la laminina, de manera que la célula se fija
‘con la matriz extracelular; esta fijacién se ve reforzada por la
protefna PB180 que une a la colégena tipo XVIL
En la lamina externa que rodea a las células musculares
se encuentra otro receptor que funciona de manera similar
a las integrins; se trata de una familia de proteinas trans-
membranales denominadas distroglucanos (fig. 3-16A y
B); éstas se unen a un complejo de proteinas especificas para
miisculos cardiaco y esquelético llamadas sarcoglucanos
(fig. 3-16C); el complejo de distroglucanos también se une a
proteinas intracelulares como sintrofina y distrobrevina,
Una unién importante es la que realizan el distroglucano a
con la laminina y el distroglucano f con la distrofina. Una
mutacin en la distrofina causa la distrofia muscular de
Duchenne,
Todas las superficies externas del cuerpo, asi como las de las
cavidades, conductos y sacos internos, se encuentran recu:
biertos por células a partir dela membrana basal del ectoder:
mo y el endodermo, conocidas de manera general como
células epiteliales, epitelio o tejido epitelial. Este tejido se
integra con una o varias capas de células y es avascular (no
contiene vasos sanguineos), pero crece sobre un tejido
conectivo subyacente rico en vasos, al cual se une mediante
tuna capa de sostén extracelular denominada membrana
basal (fig. 4-1). Con frecuencia, el tejido conectivo forma
evaginaciones denominadas papilas; es esta relacién la que
explica el nombre (del griego epi, sobre; theleo, papila)
Durante el desarrollo embrionario, los epitelios que
recubren las superficies pueden formar invaginaciones en el
tejido conectivo subyacente y formar glindulas. En conse
ccuencia, éstas conforman el parénquima (porcién secretora)
y sus conductos excretores. Por otra parte, también hay célu:
Unio
Imterceluares|
basal
Lémina hid Lami
‘ing densa bas
Tejido epitelial, estructura ubicacién en la membrana
basal
las epiteliales especializadas que funcionan como receptores
sensoriales (visidn, oido, gusto y olfato).
Las funciones del epitelio son variadas. La superficie
libre protege contra el estrés mecénico, acceso de microorga-
nismos, pérdida de agua y, por otro lado, tiene una participa-
cin importante en el sentido del tacto. En las superficies
internas su funcién, en la mayor parte de los casos, es de
absorcidn o secrecién y, en otros asos, funciona tan s6lo
como barrera de proteccién.
Las células epiteliales poseen tres caracteristicas: a) se
adhieren entre si por medio de uniones intercelulares espe-
lizadas; estas estructuras relacionadas con la membrana
plasmatica contribuyen a la adherencia y comunicacién entre
Jas células;b) la regidn basal posee una superficie de contacto
entre las células epiteliales y el tejido conectivo subyacente
denominada membrana basal, y ) tienen una regién apical
tuna regién lateral y una regién basal, cada una de ellas con,
funciones diferentes (fig. 4-1)
En algunos sitios se presentan células epiteiales que
carecen de superficie libre, por ejemplo las células de Leydig
en los testiculos o los islotes de Langerhans en el pancreas.
Algunos autores designan a estas células como tejido epite
lioide, si bien estas células presentan citoqueratina en su cito-
plasma. En cambio, los macr6fagos del tejido conectivo
activos aumentan de tamafio y se acumulan hasta adquirir
tun aspecto epitelial; éstos si representan verdaderas células.
epitelioides debido a que pertenecen al tejido conectivo.
La forma que los epitelios adoptan depende de las funciones
para la cual estan diseftadas las células, La clasificacin habi-
tual es descriptiva y se fundamenta en dos factores: la forma
de las células de la capa superficial y la cantidad de estratos
celulares (capas) a partir de la membrana basal
Las células superficiales que componen un epitelio se
describen con base en su altura como planas (o escamosas),
cuando son anchas y de baja altura; cabicas (0 cuboides), si
4 ancho, la profundidad y la altura son de un tamaho simi-
CaPiruLo 4, Tesbo EPTEUAL
ne
Plano ore)
rere)
ce
Estatificado
simple
Estratos del
epitelio
Altura de las células y estratos del epitelio de revestimiento
A Reet get 8
Sales cs aA
LER Sn
‘A. Fotomicrografia que muestra el endotelio (fechas). H y EB. Fotomicrograia en la que se abserva el epitelio cibico simple (lech)
Hy E.€ Fotomicrogratia que muestra el epitelio clindrico simple (lave) con microvelosidades (Hlechas). H y ED. Fotomicrografia en le que se
identifica el epiteliocilindrico simple (lave) con cilios flechas). Hy
Clasifcacién de los epitelios
t A. Fotomicrografia que muestra el epteia plano estratificado quetatnizado lave); obsérvese la capa de céllas queratnizadas (lech.
HE. B. Fotomicrografia en la que se reconace el epitelio plano estraiicado no queratinizado (llave); nétense las élulas superfciales nucleadas
(fechas) Hy E.€. Fotomicrogratia que muestra el epitelio seudoestatficado clinrico(Ilave) con cis lecha).H y E. D.Fotomicrografia en la que
se observa el epitelio seudoestratificado cilindrco(llave) con estereociis (lechas).H y €. €. Fotomicrografla que revela el epitelio cibico estat
«ado (flecha).Tincién de Van Gieson. F.Fotomicrograia en la que se identifica el epiteio de transcién (llave); obsérvense las células de la capa
superficial en forma de cipula(Mlechas). Hy E.
far, y cilindricas (o columnares), cuando la altura es mayor
que las otras dimensiones. En cuanto al nuimeto de estratos
celulares, el epitelio se describe como simple, si tiene una
sola capa de células, estratificado, cuando posee dos o mis
capas celulares (fig. 4-2)
En algunos casos puede aftadirse un tercer factor a este
sistema de clasificacién (la especializacién de la regidn celu-
lar apical): ciliado, cuando la regién celular apical presenta
cilios; y queratinizado o no queratinizado, si tiene 0 no
queratina, o con microvellosidades.
Dos categorias especiales de epitelio son el transicional
yel seudoestratificado, El epitelio de transicién (urotelio)
reviste las vias urinarias desde los célices menores del rifién.
hasta el segmento proximal de la uretra y tiene caracterist
cas morfolégicas especificas que le permiten distenderse. El
epitelio seudoestratificado parece estratficado debido a las
diferentes alturas que poseen las células, pero todas se apo-
yan en la membrana basal
Ciertos epitelios reciben nombres especificos en algunos
sitios, como el endotelio, que es el revestimiento epitelial del
68 CapiruLo 4, Tev100 EPITELIAL
sistema cardiovascular; 0 el mesotelio, que recubre las pare-
des de las cavidades pleural, pericirdica y abdominal.
Cada tipo de epitelio puede tener una o més funciones,
segiin sea la actividad de los diferentes tipos celulares que
contenga; de esta manera pueden realizar las siguientes fun
ciones: proteccién (p. ej. la piel), absorcién de moléculas (p.
gj, intestino), secrecién (p. ej. glindulas), percepcién de
estimulos (p. e. epitelio olfativo), transporte (p. ¢., células
ciliadas del epitetio respiratorio) y contraccién (p. ¢). célu-
las mioepiteliales).
Los diversos tipos de epitelios y su clasificacién se ilus-
tran en las figuras 4-2, 4-3 y 4-4 y en el cuadro 4-1
En consecuencia, losepitelios simples y en algunos casos
los seudoestratificados son estructuras que participan en la
absorcién o la secrecién y en ellas la altura de las células es
con frecuencia reflejo de sus actividades. Los epitelios planos
simples llevan a cabo en gran proporcién el transporte trans-
epitelil
Los epitelios estratificados suelen proporcionar imper-
meabilidad y ademés las células basales son precursoras
(células madre) que dan origen a nuevas células funcionales
del epiteli.
Caracteristicas citolégicas
especializadas de los epitelios
Las células epiteliales se caracterizan por la tendencia a for-
‘mar membranas y en general éstas se adhieren con firmeza
‘unas con otras en sus superficies laterales mediante especia-
lizaciones de la membrana en la regién lateral. La superficie
libre puede presentar una forma especial de acuerdo con las
funciones del epitelio. El extremo distal de la célula o regién
apical es diferente al extremo proximal o regién basal, por
lo que las células tienen polaridad; a menudo esta ltima se
‘manifiesta cuando un conjunto de protefnas se desplaza den-
tro de un espacio limitado de la membrana celular (fig. 4-1),
La polaridad también incluye la organizacién de los organe-
los dentro de la célula y es mas evidente en epitelios cabicos
yeilindricos.
Especializacién de la regién lateral
La regién lateral de las células epiteliales se halla en estrecho
contacto con las regiones laterales opuestas de las células
vecinas. Las uniones celulares son puntos de contacto entre
las membranas celulares, lo cual permite la formacién de
estratos 0 capas subyacentes con permeabilidad selectiva, a
su vez convertidos en barreras mecénicas muy fuertes. La
regién lateral, al igual que las otras regiones, se caracteriza
por la presencia de proteinas exclusivas denominadas molé-
culas de adhesién celular; ademas, en algunos epitelios la
membrana celular lateral forma pliegues y prolongaciones,
invaginaciones y evaginaciones que crean entramados entre
las células vecinas, Las estructuras reveladas con el micros-
copio electrénico que componen una unién celular son la
zonulae occludens, zonulae adherens, macula adherens y
nexo (fig. 4-5).
La zomulae occludens, unién estrecha 0 unién oclusiva,
es una verdadera barrera de difusién y suele ser la més apical.
El término zonulae indica que la unién forma una banda que
Zonuloe occludens
Zonuie adherens
Mocula adherens
Uniones tipo nexo
1 Figura 4-5. A. Esquema que ilustra las uniones celulares. 8. Micogratia en donde se correlacionan las leyendas del esquema. Microscopiaelectio-
nica de transmisién,
Coraceristiasctoligicas expeciazadas de los eptelos EIN
Cuadro 4-1. Epitelios de revestimiento y clasificacién
Plano simple vvasos (endotelio) Barrera
‘avidades corporales Intercambio
Alveolos respiratoios
Cabico simple CConductos de glandulas exocrinas _Conduccién
Tobulosrenales Absorcin
Superticie del ovario Barrera
Secrecién
Glindkico simple Vesiculabitar Absorcién
(con y sin velloidades) Estémago Secrecién
Intestino delgado
Golon
Seudoestratticado Trdquea ssecrecion
Bronquios Conducién
Conducto deferente Absorcidin
Plano estratficado no queratinizado Vagina Barrera
Cavidad ducal Proteccon
s6fago
Plano estatficado queratinizado Eiders Barrera
Proteccién
Cubico estratticado Conducts de olindulas sudoriparas Barrera
Unin anorrectal Conduccién
(De transicién distendido y aptanado ——Caices Barrera
Ureteres Distensbilidad
Veja
Uretra
Glindrico estratificado Conductas mas grandes de Barrera
léndulas exocrinas Conduccién
Unién anarrectal
a
pees
70 Capito 4. Tes00 ePTELAL
Membrana
cellar
Puntos o
fusiones
Membrana
collar
1 Figura 4-6. Microgatia en la que se observan los puntos de union en
ef espacio intermembranal. Iécnica de crifractura.
rodea por completo a la célula, mientras que occludens hace
referencia a la fusién de membranas que tiene lugar en estas
uniones y que cierra el espacio intercelular (fg. 4-5).
Mediante la técnica de criofractura y un microscopio
electrénico se observa que no se trata de una linea o sello
continuo, sino mas bien de una serie de fusiones focales entre
las células, EI niimero de lineas y surcos muestra una gran
correlacién con el grado de permeabilidad del epitelio (fig.
4-6). Los epitelios que presentan escasas zonas de fusién tie~
nen una permeabilidad mayor al agua y solutos que los epi-
telios con numerosas zonas de fusidn.
Por lo tanto, las funciones principales de este tipo de
tunién son las siguientes:
+ Prevenir la difusién de moléculas entre células adyacen-
tes y contribuir de esa forma a la funcién de barrera.
+ Evitar la migracién lateral de proteinas especializadas de
membrana y participar en la formacién de comparti-
mientos funcionales delimitados
En la zonulae occludens hay tres tipos de proteinas prin-
cipales transmembranales:
+ Ocludina, la primera proteina en descubrirse en este tipo
de unin; tiene un peso de 60 kDa. Interviene para man-
tener la barrera entre las regiones apical y lateral; esta pre-
sente en la mayor parte de las uniones oclusivas; sin
‘embargo, varios tipos de células epiteliales carecen de esta
proteina, aunque también poseen otro tipo de zonulae
‘occludens bien desarrollado y funcional.
+ Claudinas, familia descubierta s6lo hasta fecha reciente y
cuyos miembros son componentes integrales de las hebras
de cierre de la zonulae occludens (20 a 27 kDa). Tienen la
capacidad de formar canales acuosos extracelulares para
el paso de iones y otras moléculas pequefias. De esta
familia se han identificado alrededor de 24 miembros.
+ Molécula adhesiva de unién, proteina que pertenece ala
superfamilia de inmunoglobulinas de 40 kDa. Se relacio-
na con las claudinas para formar hebras de la zonulae
‘occludens. Participa en la unién de una célula endotelial
con otra, asi como en la unién monocito-célula endote
lial durante la migracién desde la luz del vaso hasta el
tejido conectivo.
Por iiltimo, la funcién que desempefa la zonulae occlu
dens es esencial para el paso selectivo de sustancias de un
lado a otro en un epitelio, La capacidad de crear una barrera
de difusién en los epitelios depende de dos mecanismos que
cefectian el transporte de sustancias:
La via transcelular se lleva a cabo a través de la mem-
brana plasmatica de la célula epitelia; en la mayoria de los
casos el transporte es activo y requiere canales y proteinas
transmembranales y consume energia. Estos canales despla-
zan sustancias seleccionadas desde la regién apical hasta el
citoplasma y luego ala regidn lateral por debajo dela zonulae
‘occludens en direcci6n del espacio intercelular (fig. 4-7).
La via paracelular tiene lugar a través de la zonulae
‘occludens entre dos células epiteliales. Esta permeabilidad
depende de la composicién molecular de las hebras de cierre
¥ por tanto de la cantidad de canales acuosos activos en el
sellado (fig, 4-7).
La zomulae adherens, o z6nula adherente es un tipo de
‘contacto que se encuentra inmediatamente por debajo de la
zonulae occludens. Aunque en esta iiltima hay una fusién de
membranas celulares contiguas, su resistencia ante el estrés
mecinico es limitada. La zomulae adherens, de disposicion
lateral al igual que la zonulae occludens, se presenta en forma
de cinturén continuo alrededor de la célula, Por otra parte, la
unién entre dos células también puede mostrar caracteris
cas laminares en lugar de anulares, la denominada fascia
adherens, que estabiliza tejidos no epiteliales; y las adhesio-
nes focales 0 contactos de fijacién, que proveen una adhe
rencia precisa y relacionan la célula con componentes de la
matriz extracelular,
Zonulae
accludens
va Via
transcelular paracelular
1 Figura 4-7. Vias para el transporte de sustancias a través de los epi
telios.
Ecadherna Ca" Acting
rae
I
(}
aii?
0
a
Ss
Membranas
contiguas,
Caterina
Corecterstiascoligices expecialzade de los epitelos
1 Figura 4-8. a. viagrama de la organizacién molecular de la zonuloe adherens. B. otomicogrataen la que Se abserva la postvded para E-cadhe
‘ina entre las células epteliales. inmunohistoquimica,
Investigaciones inmunohistoquimicas y biomoleculares
han demostrado que las placas de la z6nula adherente se
componen de una molécula de adhesién celular depen-
diente de calcio llamada E-cadherina, que es una proteina
transmembranal. En el lado citoplasmatico, la E-cadherina
se une a la catenina y ésta a su ver a la vinculina a la
@-actinina para finalmente interaccionar con los filamentos
de actina del citoesqueleto (fig. 4-8). Las moléculas de E-
cadherina median asi la verdadera unién de las células.
Las moléculas de E-cadherina dependen de iones calcio
para un funcionamiento correcto; por lo tanto, la elimina-
cidn de iones calcio del medio extracelular trae como conse-
cuencia la disociacién de estas proteinas yla disolucién de la
unién,
Flamentos
intermedios
Desmogleina y
esmocoina
(pacoglobina y
desmoplaquna)
Membranas
1 Figura 4-9. A. diagrama de 1a organizacién de un desmosoma
B. Micrograffa de un desmosoma. Microscopia electrnica de transmi-
sién,
bilidad mecanica a las células epiteliales expuestas a estrés y a
fuerzas de cizallamiento y esta particularmente bien desarro-
llada en el epitelio plano estratificado queratinizado que cubre
lapel. A diferencia de las untones celulares anteriores, los des
‘mosomas no adoptan forma de cintas y tienen una forma casi
circular; se encuentran dispersados en la regién lateral de las
células y en casi todas las capas epiteliales.
Con la microscopia electronica se comprueba que la
estructura de los desmosomas es compleja. El espacio inter:
celular es mas ancho que el resto de las uniones celulares,
ocupado por una banda central densa o linea intermedia,
que corresponde a la unién de dos tipos de proteinas trans-
membranales: las desmogleinas y las desmocolinas (perte-
necientes a la familia de las cadherinas), dependientes de
calcio, Estas proteinas se unen en el lado citoplasmatico
de cada una de las células contiguas a una placa discoide de
‘material denso llamada placa de adhesin del desmosoma,
quea nivel molecular se encuentra constituida por las prot
nas pacoglobina y desmoplaquina (fig. 4-9)
Las placas densas son un sitio de fijacién de filamentos
intermedios que convergen hacia los desmosomas, pero no
finalizan ahi sino que forman un lazo en horquilla en la placa
densa, regresan al citoplasma y se alejan del desmosoma.
Los nexos, gap, uniones de hendidura 0 comunican-
tes, es decir, uniones comunicantes, permiten la difusion
selectiva de moléculas entre las células adyacentes, como
iones, moléculas pequefias, nutrientes y quiz desechos celu-
lares, ademés de facilitar la comunicacién directa entre una
célula y otra (fig. 4-10). Se localizan sobre la regidn lateral de
las células epiteliales y tienen gran importancia en los tejidos
en los que la actividad de las células contiguas debe estar
coordinada, como en los epitelios ocupados en el transporte
de liquidos y electrélitos.
CaPiruto 4, Te00 ePrTELIAL
(Tr
0 fH) wt
Diagrama y miciogatia de la membrana basal y sus
Componentes. microscopia electnica de transmision.
A diferencia de la zonulae occludens, en las membranas
plasmaticas los nexos no se encuentran fusionados, sino
separados por espacios estrechos.
Con la microscopia electrénica es posible demostrar
{que las subunidades que forman cada nexo son dos hemica-
nales de estructura cilindrica hueca lamados conexones
incluidos en las membranas. Estos canales estin formados
por pares de conexones que cruzan el espacio extracelular
entre células contiguas. El conexén de una membrana celular
std alineado con precisién para acoplarse con un conexén
coincidente de la membrana de la célula contigua y asi posi-
bilitar la comunicacién (fig. 4-10A y B).
Cada conexén esta formado por seis subunidades simé-
tricas de una proteina integral de la membrana llamada
‘A Diagrama de la organizacién de una unin tipo nexo.
1. Micrografla que muestra uniones tipo nexo contrastadas con tincién
negativa (lecha). MiroscopiaelectrGnica de transmisién.
Lamina
us Fibionectna
Fotomicrografia que muestra la postvdad de a mem
bana basal la tenia de PAS Diagram dela organizaciin de una adhesion focal
‘conexina, En consecuencia, cada canal completo se integra
con 12 unidades de conexina, que se agrupan de manera cir-
cular para formar un canal ciindrico que permite el paso de
moléculas solubles hasta un peso de 1 000 Da. También se ha
demostrado que es posible variar el diimetro del conducto y,
en consecuencia, su permeabilidad, Por ejemplo, un aumen-
to de la concentracién de iones calcio promueve el cierre de
Jos nexos; la permeabilidad también depende del potencial
de membrana de la célula.
Especializacién de la regién basal
Varios elementos conforman la superficie basal de las células
epiteliales: la membrana basal, las uniones célula-matriz,
‘extracelular y los repliegues de la membrana celular basal.
La membrana basal es una estructura especializada que
se encuentra junto ala superficie basal de las células epitelia-
les y el estroma del tejido conectivo subyacente. Para que la
‘membrana basal pueda reconocerse al microscopio, se requie-
ren técnicas especiales de tincidn (dcido peryédico de Schiff),
debido en parte a lo delgado de esta capa y su composicién
(fg. 4-11).
Mediante microscopia electrénica se pueden distinguir
diversos componentes estructurales de la membrana basal
(fig. 4-12); inmediatamente debajo de la membrana celular
se distingue una capa electrolicida denominada lamina
Ticida, que se continia con una capa més electrodensa
compuesta por un reticulado fino, la denominada lamina
densa, En conjunto, la Kamina densa y la lamina licida con-
forman la lamina basal. Por debajo de la limina basal se
‘encuentra una zona més variable, compuesta por fibras reti
cculares incluidas en una sustancia fundamental conformada
por proteinas y polisaciridos. A esta zona se la conoce como
lamina reticular.
De esta manera, la lamina basal en conjunto con la lami-
na reticular integra la membrana basal, que se puede definir
con el microscopio dptico.
El analisis de membranas basales provenientes de varios
epitelios indica que esti compuesta por cuatro grupos de
Flamentos
intermedios
Integina
Placa de adhesion
Coractristicascitlégicas especiazades de losepitelios, EI
proteinas: colagenas de al menos tres tipos, la més abundan-
te de las cuales (50%) es la colagena tipo IV; lamininas, glu-
coproteinas con forma de cruz que son indispensables para
iniciar la configuracién de la lamina basal y que ademés par-
ticipan en muchas interacciones célula-matriz extracelular;
entactina, una glucoproteina sulfatada que funciona como
vinculo entre la red de coligena tipo IV y la laminina; pro-
teoglucanos, complejos que consisten en un centro proteico,
al cual se fijan cadenas laterales de glucosaminoghucanos
aniénicos, por lo cual permanecen muy hidratados; estos
complejos le proporcionan una gran parte del volumen a
Ja lamina basal y desempeftan una funcidn importante en la
regulacién del paso de iones.
La kimina basal cumple varias funciones esenciales. Por
una parte, actiia como apoyo del epitelio dado que permite la
fijacién del epitelio a la matriz extracelular.
Por otra parte, acta como filtro molecular pasivo al
retener moléculas segin sean su tamaiio, forma y carga eléc-
trica. También funciona como filtro celular al permitir el
transito de ciertas células relacionadas con las defensas con-
tra microorganismos invasores e impedir el paso de otros
tipos de células hacia el epitelio. Sirve como una guia 0 arma-
z6n para la regeneracién de los epitelios; influye sobre la
diferenciacién y organizacién celular, dado que las molécu-
Jas de la matriz extracelular reaccionan con los receptores de
la superficie celular y asf actian como moléculas de seftaliza-
i
Las uniones célula-matriz extracelular, las uniones
adherentes que se encuentran en esta regién, mantienen la
integridad morfol6gica del tejido epitelial y la matriz extra-
celular. Las dos principales son las siguientes:
1. Adhesiones focales 0 contactos focales. Crean un enlace
dindmico entre los filamentos de actina del citoesqueleto
y las proteinas de la matriz extracelular. Desempefian una
funcién principal durante la migracién de las células epi-
teliales durante la reparacién del tejido.
La familia principal de proteinas transmembranales
que intervienen en las adhesiones focales es la de las inte-
Lamina
lcida
Lamina
densa
Figura 4-14. piagrama y microgratia de un hemidesmosoma. Microscopia electrénica de ransmision
CCaPiTuLo 4, Tesbo ePrTELAL
Supertici apical
cove
SRST sees stacks
Tonula de
‘clusion
Bs — tonvla de
adhesion
Pe
esmnosoma
Q as
ee
la membrana
Diagrama y microgratia de los piegues de la membrana celular basal (Hlechas). Microscopiaelectrénica de transmision.
grinas, en relacién con la cara citoplasmatica de las adhe-
siones focales; las integrinas se unen a un
proteinas denominadas talina, vinculina y pa
son fijadoras de actina. En el lado extracelular, las integri
nas se unen a glucoproteinas de la matriz extracel
por lo general a laminina y fibronectina (fig. 4-13).
Hemidesmosomas. Se componen tan s6lo de la mitad de
tun desmosoma y Ginicamente se encuentran sobre la
superficie basal de las células epiteliales. De este modo,
los hemidesmosomas median contactos entre las células
y la matriz extracelular. Tienen una funcién de fijacién
distinta respecto del desmosoma; ademés, es caracteristi
‘co que los filamentos intermedios terminen en la placa
sin formar lazos como los desmosomas (fig. 4-14),
Membrana Actina
Fimbrina
=
Filamentos
intermedios
Diagrama y micogratia de microvellosidades, Miciosco
pia electrénica de bartido.
Las proteinas transmembranales en los hemidesmoso-
‘mas no son cadherina, como en el desmosoma, sino pro!
ns pertenecientes a la familia de las integrinas, las cuales se
tunen a una placa de adhesién en la parte interna celular ya
los componentes de la matriz extracelular en la parte extra:
celular, tal y como se observa en las adhesiones focales.
Los repliegues de la membrana celular basal aumen:
tan la superficie en las células que transportan liquidos, lo
{que permite que haya més proteinas transportadoras y cana-
les (fig. 4-15). Es comtin observar una cantidad considerable
de mitocondrias orientadas verticalmente dentro de los
repliegues, debido a la gran cantidad de energia que esta
zona requiere; por otra parte, esta conformacién le confiere
tun aspecto estriado, que en algunos conductos como los de
las glindulas salivales se llaman conductos estriados.
La superficie libre de algunas células epiteliales presenta
‘modificaciones cuyo objetivo es incrementar la propia super-
ficie o desplazar particulas.
Microvellosidades
Con el microscopio éptico a gran aumento se distingue en
algunos epitelios cilindricos un borde refringente a lo largo
de la regi6n apical. A veces se ve sobre ese borde lineas ver-
ticales, de donde deriva la designacién de ribete, borde
estriado o borde en cepillo (fig. 4-16). Con el microscopio
electrénico sobre la membrana plasmitica de las microvello-
sidades se identifica un recubrimiento filamentoso externo
(PAS positivo) que corresponde al glucocdliz (fig. 4-17).
‘Mediante microscopia electrénica, la mayor parte de las
células de los distintos epitelios muestra pequeitas proyec
ciones en el citoplasma. Estas proyecciones aparecen en can:
Figura 4-17. A Fotomicrogatia ue muestralapositvided del glucocd-
ig gratia q
liz ala técnica de PAS. 8. Miciogafia que muestra el glucocdliz que
recubre las microvellosidades. microscopia eletrénica de transmisin.
tidades variables, pueden ser expansiones cortas o largas
digitiformes, o bien pueden mostrar un trayecto sinuoso.
Las células que tienen una elevada actividad de absor-
cién poseen una gran cantidad de microvellosidades. En
estas células, el glucocaliz es mas grueso que en la mayoria de
las células, de tal forma que se pueden observar ambas
estructuras al microscopio dptico.
En el interior de las microvellosidades hay grupos de
filamentos de actina que, por medio de otras proteinas, man-
tienen enlaces cruzados entre si y con la membrana plasm-
tica de estas estructuras.
La funcién de las microvellosidades es aumentar la
superficie libre luminal, por lo que se encuentran microve
Ilosidades en epitelios especializados en absorcién.
= *
c. Membrane
cela
Microtibulos
centrales
&
& fy]
at
Dobletes
Tipetes
(308
ey
Cuerpo basal
Coractaticas cholic expecazads de lov eplaos
Estereocilios
Son prolongaciones largas e inméviles que presentan las
células del epididimo y el conducto deferente. Se considera
que son inméviles, por lo que se los conoce con ese nombre
para diferenciarlos de los cilios verdaderos. Con el microsco:
pio éptico se demostré que son microvellosidades muy lar
gas, que carecen del complejo filamentoso central. En
‘consecuencia, son flexibles y se enroscan entre si lo cual les
confiere un aspecto de penachos al microscopio éptico.
Secree que a funcién de los estereocilios es incrementar
cl drea de la superficie celular y facilitar el movimiento de
moléculas hacia el interior y el exterior de la célula en el epi-
didimo y el segmento proximal del conducto deferente.
Cilios o fimbrias
Son estructuras largas con motilidad y se localizan en la
superficie apical de algunas células epiteliales. Mediante
microscopia electrénica se puede observar que estas estruc-
turas estin rodeadas por membrana plasmatica y contiene
tun complejo interno de microtibulos longitudinales deno-
minado axonema, En cortes transversales se advierte que
este complejo se compone de nueve pares (dobletes) de
microtibulos periféricos y dos microtibulos individuales
(singletes) centrales; esta disposicién de microtubulos repre-
senta un patrén de “9 + 2” (fig. 4-18A y B).
El corte transversal muestra la configuracién caracterist-
ca (9 + 2). Los microtibulos que componen cada doblete se
denominan tibulo A y tibulo B; el primero presenta una
pared completa de 13 protofilamentos, mientras que el segun-
do contiene 10 protofilamentos y comparte tres con el tibulo
‘A.A partir de cada hilera de tibulos A se extienden dos hileras
de brazos en direccién del tibulo B del préximo doblete; los
1 Figura 4-18. a. oiagrama de un clo y su cuerpo basal. 8, Micrografia de un clio cortado de manera transversal; obsérvese la disposicion de los
microtibulos en un patron de 9 + 2. Microscopia electronica de transmisin. €. Micografia del cuerpo basal de un clio; se reconoce el patrén de
rnueve tripletes de mirotibulos. Microscopia electronica de transmisién,
76 CaPtruLo 4. TeDO EPITELIAL
ago Secrecion
esiculas ae
Aparato
e Golgi
eR
Nodleo
Meroctina Apoctina
bla
madura
secretada
vaso
sanguineo
Pee Membrana
basal
Holoctina
Endocrna
T Figura 4-19. Tipos de secrecion en las glandulas exoctinas multicelulares. RER, reticulo endoplésmico rugoso.
brazos estin compuestos por una proteina motora llamada
dineina cilia. Por otra parte, un componente elistico formado
por nexina vincula en forma permanente los tubulos A y B.
Los cilios estan insertados en los cuerpos basales, que
son estructuras electrodensas similares a centriolos situados
na porcién apical, inmediatamente por debajo de la mem-
brana, y consisten en nueve tripletes de microtibulos cortos
organizados en un anillo (fig. 4-18C).
El movimiento que presentan los cilios es oscilatorio y
1crdnico; las células de un epitelio ciliado estan organiza-
das a menudo para que aparezca una corriente de liquide 0
particulas que se dirige en una direccién concreta a lo largo
de la superficie del epitelio.
Flagelos
La estructura de los flagelos, que en el cuerpo humano slo
se presenta en los espermatozoides, es similar a la de los
cilios, aunque los flagelos son més largos y constituyen una
estructura tinica en cada célula. Los flagelos tienen wna for-
made movimiento distinta respecto de los cis, pero la base
‘molecular de esos movimientos es igual.
Adaptaciones secretoras
(glandulas)
Ciertas células epiteliales tienes especializaciones estructura-
les relacionadas con su funcién en la produccin y secrecién
dde moléculas (enzimas, mucinas y esteroides). Ademis, las
células epiteliales pueden adaptarse para la sectecién y trans-
porte de iones. Estas células se caracterizan por una expan-
sin en su sistema de organelos especificos que intervienen
cen la elaboracién y secrecién de macromoléculas.
La secrecién del producto celular se lleva a cabo por tres
diferentes mecanismos basicos por parte de las células epite-
liales (fig. 419).
Secrecién merocrina E] producto de secrecién se empa-
queta en vesiculas imitadas por membrana y con posterioti-
dad se dirigen a la periferia de la célula hasta fusionarse con
la membrana plasmética para vaciar su contenido por exoci-
tosis, por ejemplo en células acinosas del péncreas (fg.
420A).
Secrecién apocrina. E| producto de secrecién se libera
cen la regidn apical de las células, envuelto en pequefias vesi-
1 Figura 420. . Fotomicrogratia que muestra clulas con mecanismos de secrecdn meroina; obsérvense lo grnulos en la pocién apical (fechas).
HE. B.Fotomicrografi en la que se Kentificanceuls con sececionapoctina;destacan los grnulos con pociones de citoplasma (lech) Hy E
Fatomicrografiaque muestia lla con sececonholacina;nétense los restos cellres (echas). Hy E
las rodeadas por membrana plasmética y una pequefia
tidad de citoplasma, por ejemplo en glindulas mamarias,
fig. 4-208).
Secrecién holocrina. El producto de secrecién se acu-
la dentro de la célula en maduracién hasta que sufre una
ste programada y libera todos los productos, incluidos
restos del contenido celular hacia la luz de la glandula; las
ndulas sebaceas de la piel son un ejemplo (fig. 4-20).
Las glindulas se clasifican en dos grupos principales de
erdo con el destino de su secrecién. Las glindulas exo-
liberan el producto por medio de un sistema de con-
ictos que se abren a una superficie externa o interna,
jentras que las gkindulas endocrinas lo liberan a la sangre,
10 hormonas. Algunas células glandulares liberan el pro-
cto hacia el interior del cuerpo, pero no ala sangre, sino a
células préximas, mediante un mecanismo denominado
scién paracrina como se describe en la figura 4-21
En muchos epitelios, la secrecién la realizan células
ializadas (células caliciformes secretoras de mucina),
__ rant
xocrinas
as
Adaptaconessecetoras (génduas) ZI
que se encuentran dispersadas entre otras células no secreto-
ras, Cuando se necesita mayor cantidad del producto de
secrecién, la superficie del epitelio puede aumentar, invagi-
narse y formar glindulas tubulares rectas, espirales o ramifi-
cadas més complejas, que se pueden dividir en zonas
cespecializadas para la secrecién de diferentes productos.
Las glindulas exocrinas se clasifican en unicelulares y
multicelulares. Una ghkindula unicelular se compone de una
célula secretora tinica. En los mamiferos, el tinico ejemplo es,
acétula caliciforme, que se encuentra en diversos epitelios de
membranas mucosas. Una célula caliciforme llena se observa
con miitiples gotitas de secrecién acumuladas en la region
apical, que se torna més ancha, mientras que en la region basal,
en donde se encuentra el niicleo es més angosta. La célula
adopta asi una forma de ciliz (fig. 4-22A, By C).
‘Alas ghindulas multicelulares ms simples se les deno-
‘mina superficie epitelial secretora, debido a que se compo-
nen de una capa epitelial de células secretoras de un mismo
tipo.
=
sin conducto. —
Endocrnas
NNimero de células
Figura 4-21. Algoritmo que muestra la clasifcacion de las glandulas.
—_—— =
none peace Unicelulares ‘Multicelulares
Ges ios aa
Forma del Forma de la uni- Tipo de ‘Mecanismo eee oes
conducto dad secretora secrecién de secrecién ae Foliculos Cordones
seg || ipdtisis Tiroides Suprarrenal
fe ee ay ee
Tubular
simple
| am | an
— cog |) See
-enrollada |
Tubular simple pais (pancreas
Tubular Mixta ‘Holocrina
= oe
78 CAPITULO 4, TENIDO EPITELAL
a Microvellosidades 8
Tea
Gotitas de
mucindgeno
Tallo
1 Figura 4-22. .squema que usr una cll calor, su ei
nes lo componentes queen ella se encuentran Fotomicrogaa
Que muestra una cll calilome (lave), observes nice (1) y
Tos grdnuls de secrecin (2) en traques. Hy E €- Mirogratia que
muestra células caliciformes con sus ndcieos (1) y granulos de secre-
Gin (2). Mcoscopia electénica de vansmisin,
Conducto
Parca
secretora
Tubular simple Tubular simple ramificada Tubular envolada ‘Acnar simple Acinar simple ramificada
Tubular compuesta ‘Acinar compuesta Tubuloacinar compuesto
1 Figura 423. candles excrinas multiceulares.
‘Adaptaciones secretoras (glandulas)
igura 4-24. A Fotomicrografia que muestra un ejemplo de gléndula
tubular simple (lave). H y €. 8. Fotomicrografia en la que se observan
léndulas tubulares simples ramifcadas (lave). H y E. €. Fotomicro-
dafia que muestra un ejemplo de glandula tubular simple enrolada
(lave); obsérvese la porcion conductora (1) y secretora (2). H y E.
©. Fotomicrografia en la que se reconacen las glindulas acnares sim
ples (lave). Hy EE. Fotomicrografia que ilustra un ejemplo de glindu-
{a acinar simple ramificada (lave); nétense las porciones conductores
(1) y secretoras (2). Hy €.
CAPITULO 4, TeDO EPrTELAL
A Fotomiciografia que muestra un ejemplo de glandula
tubular compuesta; se observan ls porcones conductaas (1) y secre
toras (2). H yE.B.Fotomicrografia de glindulas acinares compuestas
tense la porcion conductora (1) y las acinos secretores (2). Hy €
Fotomicrografia que muestra glandulas tubuloacnares compuestas,
obsérvense las porciones conductoras (1) y los acinos secretores (2)
Hye
En el resto de las glindulas multicelulares, la superficie
secretora se localiza en el tejido conectivo subyacente. La
base de su clasificacién se debe al grado de ramificaciones
{que presenta en sus conductos excretores y el tipo de conti-
guracidn de las terminales secretoras. Por consiguiente, se
denomina simple, si su conducto excretor no esta ramifica-
do, 0 compuesto, si el conducto excretor es ramificado,
[A Fotomicrogiaia que muesta acinos de sectecién
cmacasa. Hy E & Fotamitograiaen a que se observa acin de secre
(on serosa. H y E.€ Fotomicrogratia que revelaacinos de sectecion
mixta con células mucosas con semilunas serosas (circus). H YE.
En cuanto a la configuracién de la porcién secretora, se
llama tubular si la porcién secretora presenta esa formas,
alveolar si est distendida y forma un saco 0 un alveolo: y
acinar si posee la forma de un saco, mientras que la luz es,
tubular. Algunas células presentan una porcién tubular y una,
acinosa o alveolar; éstas se conocen como tubuloalveolar 0
tubuloacinar (figs. 4-23, 4-24 y 4-25).
‘Muchas veces, las glindulas exocrinas también se clasi-
fican con base en la composicin de su producto de secre-
cién como sigue: mucosas, células lenas de mucina de
aspecto claro y vacuolado, con el micleo casi siempre aplana-
do (fig. 4-264); serosas, con un citoplasma muy baséfilo y el
pice es eosin6filo claro; el micleo es redondeado y se locali-
za en la porcién basal (fig. 4-26B), y mixtas, que contienen
células mucosas y serosas; estas iltimas son aplanadas y for-
‘man una estructura con forma de semiluna, denominadas
‘semilunas de von Ebner (fig. 4-26C).
Renovacién y regeneracion
de epitelios
‘La mayor parte de las células epiteliales tiene una vida media
finita, mas corta que la del organismo, lo cual se debe a que
lest expuesta en forma constante a acciones trauméticas,
[especialmente en los epitelios que recubren la superficie
[externa del organismo y el tubo digestivo.
Renoveciony regenera deepen EIN
Asimismo, en condiciones normales, existe una pérdida
constante de células de estos epitelios. Dicha pérdida nor-
‘mal, 0 fisiolégica, se reemplaza por medio de una regenera-
cidn fisiol6gica equivalente, que tiene lugar sobre la base de
divisiones mitéticas de células epiteliales més indiferencia-
das. Por ejemplo, en los epitelios estratificados y seudoestra-
tificados, las mitosis tienen lugar en la capa basal de éstos, en
donde se localizan células que originan estos epitelios. Tal es
el caso del epitelio superficial del estomago que se renueva
cada tres dias, o el epitelio plano estratificado de la piel, que
se renueva cada 28 dias.
El tejido conectivo o conjuntivo se caracteriza por tener
cantidades variables de matriz. extracelular, que rodea a
diversos tipos celulares (fg. 5-1).
Este tejido también se denomina de sostén, ya que se
relaciona con los tejidos epitelial y muscular a los que les
confiere soporte y rellena los espacios entre las células y los
6rganos. También forma trabéculas y tabiques en el interior
de los érganos para constituir el estroma, Dado que almace-
na lipidos, representa una reserva nutritiva. Debido a su
riqueza en mucopolisacéridos, almacena agua y electrélitos.
También almacena proteinas; se calcula que un tercio de las
proteinas plasmiticas del organismo se encuentra en los
espacios intercelulares del tejido conectivo.
Cuando se experimenta una lesién en el epitelio, el teji-
do conectivo representa también una barrera fisica contra la
diseminacién de microorganismos y la invasién de agentes
Mactéfago —___\__ [iia
Sustancia amorfa
Fibra veticula
Adipocito
Fibra colagena
Vaso capilar
patégenos, gracias a las propiedades de la sustancia funda-
mental. Los haces y redes de fibras, junto con las células
inflamatorias, fagociticas y productoras de anticuerpos,
representan una barrera biolégica de proteccién (fig. 5-2).
Ademés, el tejido conectivo transporta nutrientes de los
capilares sanguineos a los diversos tejidos y, de manera inver-
sa, moviliza también los productos de desecho del metabo-
lismo hacia la sangre.
Existen varios tipos de tejido conectivo: tejido conecti-
vo embrionario, tejido conectivo propiamente dicho y
tejido conectivo especializado.
Los tejidos conectivos se originan en el mesodermo.
Estas células proliferan y se diferencian en células mesen-
quimatosas, que proliferan, maduran y producen algunos
de los tipos celulares presentes en el tejido conectivo (fig.
5-2B); otros derivan de precursores situados en la médula
sea y migran al tejido conectivo donde desempefan su
funcién,
9 osindilo.
Sey
Fibroblasto
Fibra elastica
. plasmatica
Esquema que muestra algunos componentes del tejido conectivo.
= Celia mesenqumatosa
indterenciada
Adipcto ela
Sendo Osteblso
Foblasto Cea
meso
Condobiasto
steocto
mmadie
ematopayetca
Lnfocto 8
nate
x
(ig. 5-3), entre las que destacan la resistencia a las fuerzas de
compresién por la sustancia fundamental y la resistencia a
las fuerzas de traccién por las fibras de coligena y elésticas
que se encuentran en ella.
Sustancia fundamental
Esta sustancia, de consistencia gelatinosa e hidratada en la
que estan incluidas las fibras de colégena, se integra con glu-
cosaminoglucanos, proteoglucanos y glucoproteinas de
adhesin que unen los diversos componentes de los tejidos
centre si, Ademas de resistir a las fuerzas de compresién, la
sustancia fundamental también hace posible el intercambio
ripido de nutrientes y productos de desecho que transporta
el liquido tisular.
Fibras
Las fibras que se encuentran en la matriz extracelular pro-
porcionan resistencia a las fuerzas de tensidn y elasticidad a
los tejidos. Existen tres tipos:fibras de coligena, reticulares,
y eldsticas.
Células
En el plano estructural, el teido conectivo se caracteriza por
presentar varios tipos de células entre la matriz extracelular,
Estas células se pueden dividir en células fijas o residentes y




















También podría gustarte
- Wheater's Histología Funcional. Texto y Atlas en Color PDF60% (5)Wheater's Histología Funcional. Texto y Atlas en Color PDF421 páginas
- Netter Histología - 241120 - 102636Aún no hay calificacionesNetter Histología - 241120 - 1026361113 páginas
- Histología Humana - Stevens (3 Edición) PDF93% (30)Histología Humana - Stevens (3 Edición) PDF454 páginas
- Atlas de Histologia, Biologia Celular y Tisular - Sepúlvera Saavedra100% (2)Atlas de Histologia, Biologia Celular y Tisular - Sepúlvera Saavedra390 páginas
- Histologia.con.Correlaciones.funcionales.y.clinicas.booksmedicos.org100% (3)Histologia.con.Correlaciones.funcionales.y.clinicas.booksmedicos.org314 páginas
- Histología, Texto-Atlas Tejidos de Mamíferos100% (10)Histología, Texto-Atlas Tejidos de Mamíferos90 páginas
- HISTOLOGÍA ATLAS EN COLOR Y TEXTO ATLAS EN COLOR Y TEXTO. Leslie P. Gartner. 7.a Edición. en Línea ATLAS EN COLOR Y TEXTO45% (11)HISTOLOGÍA ATLAS EN COLOR Y TEXTO ATLAS EN COLOR Y TEXTO. Leslie P. Gartner. 7.a Edición. en Línea ATLAS EN COLOR Y TEXTO41 páginas
- Texto Atlas de Histología Gartner Hiatt 3 Edición 200888% (123)Texto Atlas de Histología Gartner Hiatt 3 Edición 2008572 páginas
- 1 Junqueira's Basic Histology Text and Atlas, 14th Edition - Compressed (001-140)100% (3)1 Junqueira's Basic Histology Text and Atlas, 14th Edition - Compressed (001-140)140 páginas
- Arteaga Martinez Embriologia Humana y Biologia Del DesarrolloAún no hay calificacionesArteaga Martinez Embriologia Humana y Biologia Del Desarrollo556 páginas
- HISTOLOGÍA Biología Celular y Tisular - Instructivo de Laboratorio0% (2)HISTOLOGÍA Biología Celular y Tisular - Instructivo de Laboratorio58 páginas
- Repaso de Histología - Un Libro de Preguntas y Respuestas100% (3)Repaso de Histología - Un Libro de Preguntas y Respuestas271 páginas
- Histologia Biologia Celular Fortoul Castell PDF100% (10)Histologia Biologia Celular Fortoul Castell PDF306 páginas
- Histología Humana - Stevens (3 Edición) PDF100% (1)Histología Humana - Stevens (3 Edición) PDF454 páginas
- Texto Atlas de Histologia Gartner Hiatt 3a EdicionAún no hay calificacionesTexto Atlas de Histologia Gartner Hiatt 3a Edicion572 páginas
- Histologia Basica Junqueira Amp Carneiro 12va Edicion 5 PDF Free 2Aún no hay calificacionesHistologia Basica Junqueira Amp Carneiro 12va Edicion 5 PDF Free 2557 páginas
- Atlas de Histología Normal: Láminas Detalladas100% (2)Atlas de Histología Normal: Láminas Detalladas117 páginas
- Introducción a la HistoembriologíaAún no hay calificacionesIntroducción a la Histoembriología17 páginas
- Introducción a la Histología y MétodosAún no hay calificacionesIntroducción a la Histología y Métodos39 páginas
- Tipos y características de célulasAún no hay calificacionesTipos y características de células8 páginas
- Cap 01 - Introducción A La Histología y Técnicas HistológicaAún no hay calificacionesCap 01 - Introducción A La Histología y Técnicas Histológica9 páginas